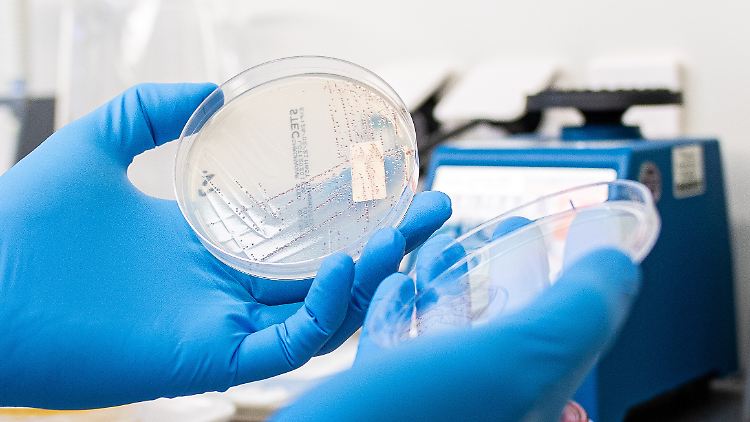

Zwei davon schwer erkrankt Noch mehr Kinder in Mecklenburg-Vorpommern mit Ehec infiziert
02.09.2025, 19:04 Uhr Artikel anhören
Bislang ist nicht geklärt, woher die Infektionen stammen.
(Foto: picture alliance/dpa)
In Mecklenburg-Vorpommern infizieren sich weiter Menschen mit Ehec. Erneut sind dieses Mal Kinder betroffen. Zwei von ihnen trifft es besonders hart: Sie erkranken am Hämolytisch-urämischen Syndrom.
Aus Mecklenburg-Vorpommern sind weitere Ehec-Infektionen gemeldet worden - es handelt sich um vier Kinder zwischen einem und sechs Jahren. Die Zahl stieg damit auf 26, wie das Landesamt für Gesundheit und Soziales (Lagus) mitteilte. Unter den vier neuen Fällen sind zwei mit der schwerwiegenden Folgeerkrankung HUS.
Ein Kind aus dem Landkreis Rostock mit dem hämolytisch-urämischen Syndrom (HUS) wird demnach in der Universitätsmedizin Rostock behandelt. Das andere Kind mit HUS komme aus Berlin, hieß es weiter. Es habe sich im Landkreis Vorpommern-Greifswald aufgehalten. Betroffen sind zudem ein weiteres Kind aus Berlin, das in Vorpommern-Greifswald im Urlaub war, und ein einheimisches Kind in Vorpommern-Rügen.
Unter den seit Mitte August in MV an Ehec erkrankten 26 Menschen sind 20 Kinder und Jugendliche. Acht der Betroffenen entwickelten laut Amt HUS, was zur Zerstörung der roten Blutkörperchen, Blutgerinnungsstörungen und Funktionsstörungen der Nieren führen kann. Von den Erkrankten würden aktuell 15 stationär behandelt. Sie seien alle in einem stabilen Zustand.
Woher stammen die Infektionen?
Die Ursache der Ehec-Infektionen ist den Angaben zufolge weiter unklar. Die Ermittlungen liefen, hieß es. Die meisten Infektionen sind bisher aus den östlichen Landkreisen Vorpommern-Greifswald und Vorpommern-Rügen gemeldet worden.
Ehec steht für enterohämorrhagische Escherichia coli und bezeichnet bestimmte krank machende Stämme dieses Darm-Bakteriums, das vor allem bei Wiederkäuern vorkommt. Die Mikroben produzieren sogenannte Shigatoxine: starke Zellgifte, die bei Menschen schwere Durchfallerkrankungen bis hin zu blutigen Durchfällen sowie HUS verursachen können. Kinder sind besonders gefährdet, weil ihr Immunsystem und ihre Organe noch nicht ausgereift sind.
Quelle: ntv.de, rog/dpa